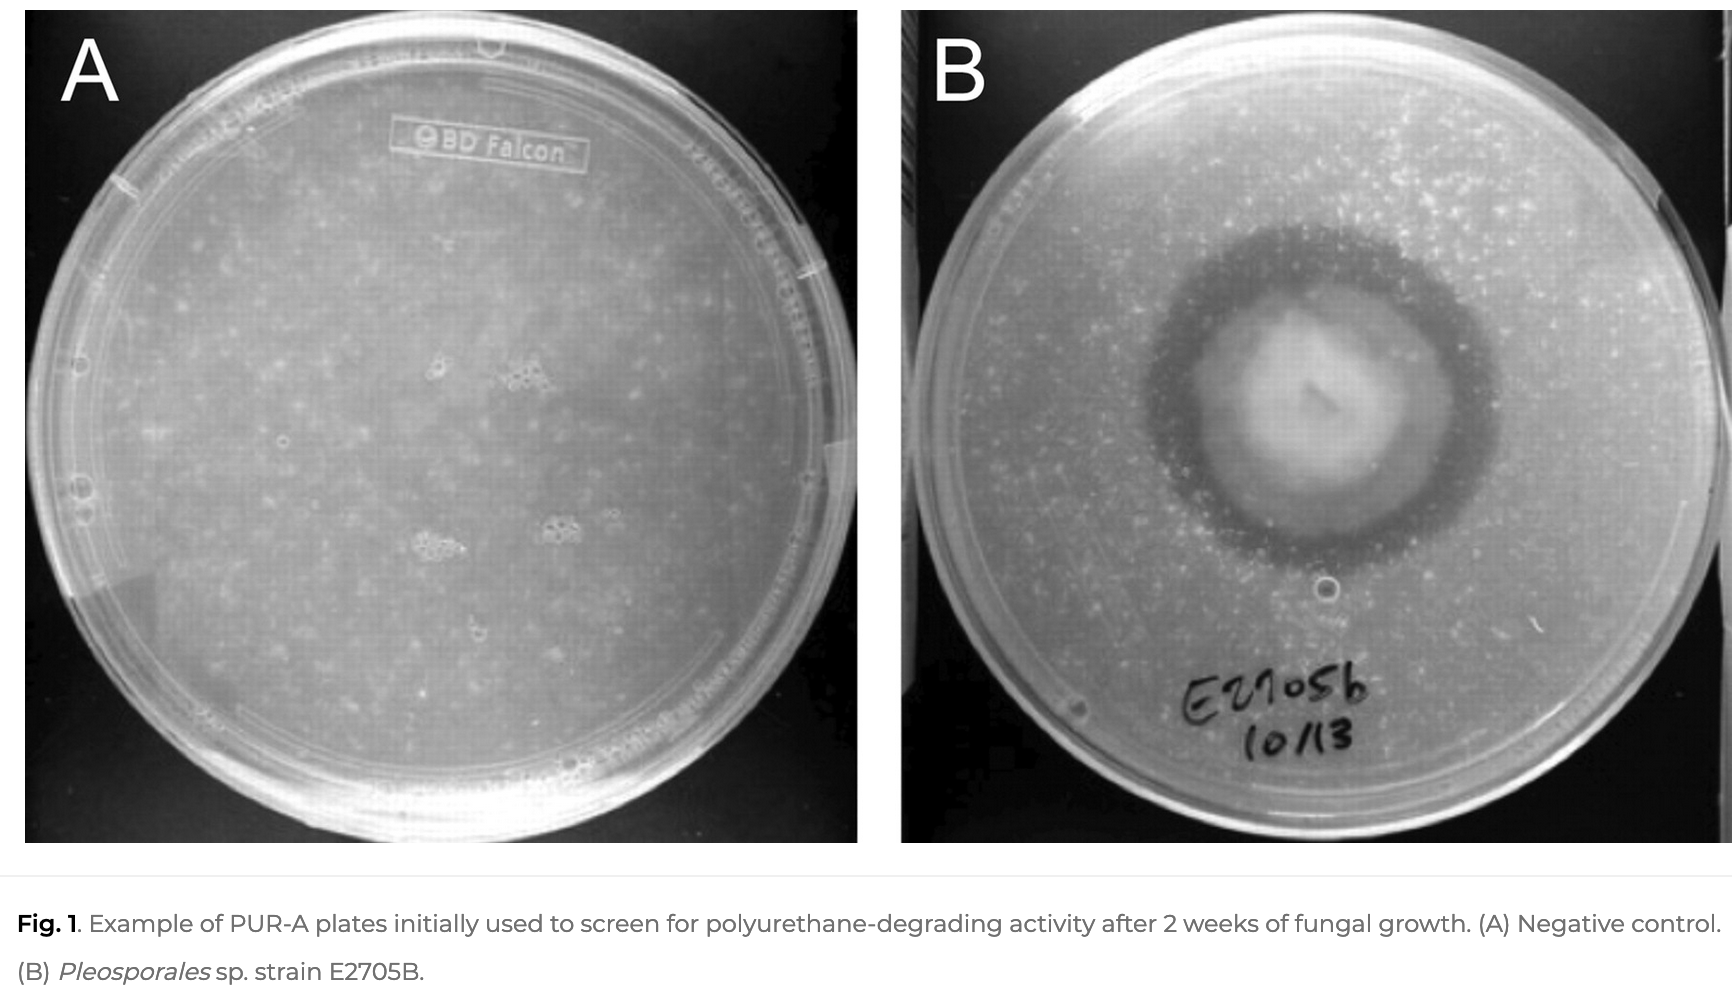

https://www.colorado.edu/ecenter/2021/11/04/plastic-eating-mushrooms In 2011, researchers at Yale University tested the ability of several dozen fungi to digest the synthetic polymer polyester polyurethane (PUR). Several members of the Pestalotiosis genus were capable of degrading PUR and converting it into organic matter. Two members of the genus were even able to survive solely off PUR in aerobic or anaerobic environments. https://journals.asm.org/doi/full/10.1128/aem.00521-11 (2011):
- Two Pestalotiopsis microspora isolates were uniquely able to grow on PUR as the sole carbon source under both aerobic and anaerobic conditions.
- Serine hydrolase is responsible for degradation of PUR.
- The fungi studied were endophytes isolated from plant stems in the Ecuadorian rain forest.
- PUR clearance screening: Growth in presence of anionic aliphatic aqueous PUR dispersion: solid and liquid media (including trace elements, amino acids, etc.), incl. 10 mL/L of a 4% PUR solution. After 2 weeks of incubation, growth was evidenced by change in medium appearance from opaque to translucent.
- Sole carbon source assay of the five most active strains: PUR solution + water and trace elements. Anaerobic or aerobic. 2 weeks observation of turbidity and increase in fungal mass.

They proved that the PUR is degraded to something else, since the ester linkage in the polyurethane polymer was broken. What are the degradation products, and are they actually less toxic than the polymer?
- Enzyme isolated that was responsible for PUR clearance: serine hydrolase.
Fungal Enzymes Involved in Plastics Biodegradation https://www.ncbi.nlm.nih.gov/pmc/articles/PMC9230134/
Biodegradation of plastic polymers by fungi: a brief review (2022) https://bioresourcesbioprocessing.springeropen.com/articles/10.1186/s40643-022-00532-4
Fungal bioremediation of polyethylene: challenges and perspectives (2021) https://ami-journals.onlinelibrary.wiley.com/doi/pdf/10.1111/jam.15203
- PE accounts for 1/3 of plastic demand in Europe
- Mycoremediation of PE has been extensively studied, but is limited by an inconclusive definition of biodegradation and a lack of knowledge regarding the biological systems responsible.
- Geyer et al., 2017: 6.8 billion metric tonnes of plastic waste have been produced prior to 2015. 20% of that waste was removed by recycling or incineration. 12 billion tonnes of plastic will be deposited in landfills or left unchecked to enter the environment by 2050 if current trends of production and waste management are maintainted.
- 12 million metric tonnes of plastic entered the marine environment in 2010 alone, and this is anticipated to increase by an order of magnitude by 2025. UV exposure and physical abrasion drive the fragmentation of plastic debris into minute particles.
- PE is a simple alkyl-chain polymer with a semicrystalline structure. It’s hydrophobic, has large molecular doimentions, and a lack of reactive groups in the polymer backbone.
Not read yet
https://journals.asm.org/doi/full/10.1128/AEM.01095-19 Plastics: Environmental and Biotechnological Perspectives on Microbial Degradation
https://www.sciencedirect.com/science/article/abs/pii/S0147651315001682 Edible fungus degrade bisphenol A with no harmful effect on its fatty acid composition
https://www.frontiersin.org/articles/10.3389/fmars.2021.738877/full The Potential Role of Marine Fungi in Plastic Degradation – A Review
https://www.sciencedirect.com/science/article/abs/pii/S0734975019302010 Fungal potential for the degradation of petroleum-based polymers: An overview of macro- and microplastics biodegradation
Conclusions
Big differences in resistance of different plastics to be biodegraded, e.g. PET and PS are easier than PVC. Some bonds in plastic polymers are similar to bonds in lignin, plant waxes, fats, etc. So fungi have enzymes that act on these bonds to some degree.
Though many studies show the degradation ability of various fungi, very few of them show effective biodegradation.
Genetic engineering could improve the ability of fungi to biodegrade plastic polymers, and enzyme engineering could improve the efficiency of isolated enzymes and enzyme cocktails to attack the bonds in plastic polymers. Strategies to make the plastic polymers more accessible to degradation by fungi or enzymes are also important, as well as mixing different strains or enzymes together to be able to degrade a wide variety of different polymers.
There have been studies of edible fungi - Pleurotus ostreatus, Pleurotus abalones, Agaricus bisporus - that degrade and can grow on plastic films.